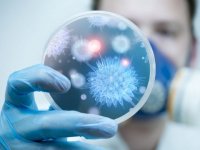

Новини за 18 листопада 2021 р.

18 листопада, 23:34 Новини
Вчені визначили, коли найкраще лягати спати, щоб мати здорове серце
Вчені визначили оптимальний час, коли треба лягати спати, щоб не мати проблем із серцем - з 22:00 до 23:00. Такі результати дослідження за участю 88 т

18 листопада, 22:58 Новини
Волинський митрополит закликає святкувати Новий рік весною
Митрополит Луцький і Волинський укотре наголосив на нашій культурній своєрідності й закликав українців не забувати про це в християнських традиціях.

18 листопада, 22:14 Новини
Біля Луцька автівка на смерть збила 18-річного хлопця. ВІДЕО
На виїзді з обласного центру Волині сталася смертельна дорожньо-транспортна пригода.

18 листопада, 21:35 Новини
У Луцьку жителі 8 вулиць залишилися без світла через помилку комунальників. ВІДЕО
Мешканці восьми вулиць у Луцьку другий день – без електропостачання через те, що комунальники перекопали силовий кабель.

18 листопада, 20:40 Новини
На польсько-білоруському кордоні померла однорічна дитина мігрантів
Близько 2 ночі рятувальники отримали повідомлення про людей у лісі, які потребують допомоги

18 листопада, 19:40 Новини
Показали, як облаштували сквер в одному з районів Луцька. ФОТО
У Луцьку завершили облаштування скверу на розі пр. Відродження та пр. Молоді

18 листопада, 19:19 Новини
Призначили нову дату аукціону з продажу Ковельської виховної колонії
Стартова ціна колонії – 41 624 692 гривень

18 листопада, 19:00 Новини
Де у Луцьку не буде світла завтра, 19 листопада
У Луцьку через ремонтні роботи завтра, 19 листопада, декілька вулиць залишаться без світла

18 листопада, 18:36 Новини
У волинському місті зроблять зелені зони у різних мікрорайонах
Виникла ініціатива розробити програму, яка б допомогла створити у різних мікрорайонах Ковеля міні-сквери

18 листопада, 17:20 Новини
Приходить повідомлення про виплати за вакцинацію: «ПриватБанк» попередив про нову схему шахрайства
Зафіксовані випадки,коли клієнтам через месенджери або електронну пошту приходить повідомлення про доступні виплати за вакцинацію на кілька тисяч грн.

18 листопада, 17:00 Новини
На Волині поліція розшукує злочинця з Тернопільщини. ФОТО
Чоловіку, який підозрюється у розбої, 20 років

18 листопада, 16:39 Новини
ЗНО-2022 на Волині: що зміниться для учасників
Реєстрація на пробне тестування для підготовки до Зовнішнього незалежного оцінювання розпочнеться 5 січня.

18 листопада, 16:27 Новини
Домініканський монастир на Волині буде приймати туристів. ФОТО
У наступному туристичному сезоні Домініканський монастир обов’язково ввійде до нового екскурсійного маршруту

18 листопада, 16:05 Новини
Волинь матиме фестивальний календар
Недопад запевняє, що інформація про те, де, коли і який фестиваль відбувається, стане у нагоді туристам, а може і окремим приводом відвідати Волинь

18 листопада, 15:45 Новини
Вдома у лучанки знайшли 3 кілограми бурштину
Обшук проводився у рамках досудового розслідування, розпочатого за фактом незаконного поводження зі зброєю та хуліганства

18 листопада, 15:40 Новини
Підробка документів щодо спадщини луцького бізнесмена Джулінського: хто за цим стоїть. ВІДЕО
У суді продовжують розглядати справу братів Джулінських.

18 листопада, 15:30 Новини
Волинські спортсмени здобули чотири медалі на чемпіонаті світу з панкратіону
Спортсмени трьох волинських борцівських клубів представляють Україну на Чемпіонаті світу з панкратіону

18 листопада, 15:25 Новини
На Набережній у Луцьку затримали вантажівку з незаконним лісом
За цією подією вже відкрили кримінальне провадження

18 листопада, 14:57 Новини
Торчинський «Колос» остаточно змінив прописку. ФОТО
Заслужений народний ансамбль пісні та танцю України «Колос» остаточно змінив прописку із Торчинської громади на Підгайцівську

18 листопада, 14:15 Новини
У селі на Волині відкрили першу в області кооперативну сироварню. ВІДЕО
Ця сироварня – перша на Волині, де господарства, що мають корів, скооперувалися задля якісного продукту.

18 листопада, 13:50 Новини
У Луцьку на авторинку викрили жінку, яка торгувала сурогатним спиртним
Громадянка, на перший погляд, торгувала чаєм та чебуреками, а пляшки з алкоголем ховала в сумці.

18 листопада, 13:30 Новини
Чи можна вагітним вакцинуватись та якою вакциною: поради луцьких лікарів
Медики радять вагітним щепитись від коронавірусу вакцинами Pfizer, AstraZeneca та Moderna.

18 листопада, 13:17 Новини
На волинській трасі запрацювала ще одна система зважування транспорту в русі
Аби забезпечити належну рівність, на 200-метровій ділянці автошляху влаштували два шари нового асфальтобетонного покриття, в яке вмонтували датчики

18 листопада, 13:03 Новини
Мігрантська криза: Рада дозволила прикордонникам застосовувати зброю
Військовослужбовці та працівники ДПС мають право застосовувати вогнепальну зброю, зокрема, для відбиття нападу на об'єкти, що перебувають під охороною

18 листопада, 12:50 Новини
У Луцьку горіла господарська споруда
Ймовірна причина пожежі - порушення правил монтажу теплогенеруючих агрегатів та обладнання

18 листопада, 12:33 Новини
У Ковелі реконструюють Привокзальну площу та будівлю міськради. ФОТО
Концепцію змін уже розробили. Планують благоустрій прилеглої території

18 листопада, 12:27 Новини
На Волині у торговому закладі вилучили безакцизні цигарки
Такий результат став можливим завдяки небайдужості громадян, які інформували про порушення на ринку реалізації підакцизної продукції

18 листопада, 12:12 Новини
Єдина школа у Луцьку відновила навчання для всіх класів через 100% вакцинованих вчителів
«Дистанційку» у школі №12 змінили на звичайних формат навчання з 16 листопада

18 листопада, 11:51 Новини
У Луцьку спіймали чотирьох п'яних водіїв: один з них пропонував патрульним хабар
За ніч патрульні затримали чотирьох керманичів з ознаками алкогольного сп’яніння.

18 листопада, 11:37 Новини
Шукав закладку: у Луцьку викрили двох наркоділків. ФОТО
На місці виявлено 30 згортків з речовиною Альфа «PVP», їх вилучили та скерували на експертизу

18 листопада, 11:18 Новини
Повідомили, які професії є найбільш затребуваними у Луцькому районі
У Луцькому районі працевлаштовано протягом 9 місяців 2021 року 2424 людини

18 листопада, 11:05 Новини
У ковідному шпиталі в Боголюбах за добу використали понад 4,6 тонн кисню
Під високими потоками кисню перебувають 137 хворих

18 листопада, 10:57 Новини
Помер волинянин, який боровся із раком останньої стадії
Надважке випробування випало на долю волинянки Людмили Цимбалюк.

18 листопада, 10:21 Новини
Розшукують 46-річного волинянина, який пішов з дому та не повернувся
Чоловік зранку 16 листопада поїхав у Ківерці та додому не повернувся.

18 листопада, 10:10 Новини
На Волині затримали 23-річного чоловіка, який мав при собі наркотичну речовину
У 23-річного пасажира, який вийшов із автомобіля, із кишені на землю випав пакетик із речовиною, ззовні схожою на наркотичну.

18 листопада, 10:07 Новини
Керівник шахти на Волині вів бізнес в так званій «ЛНР» і фінансував бойовиків
Зокрема, як підприємець він налагодив канал торгівлі продуктами харчування в ОРДЛО
18 листопада, 09:57 Новини
На Волині за минулу добу від коронавірусу померло 20 людей
Зареєстрували 685 нових випадків коронавірусної хвороби COVID-19, з них серед дітей – 59, медпрацівників – 18.

18 листопада, 09:45 Новини
На Волині навантажувач на смерть переїхав велосипедиста
Від отриманих травм чоловік помер.

18 листопада, 09:31 Новини
Через «Ягодин» намагались незаконно провезти майже пів тонни червоної риби
До легально закуплених фірмою 19,5 тонн свіжоморожених шматків лосося він довантажив у рефрижератор ще 460 кг "для себе".

18 листопада, 09:14 Новини
Знайшли солдата, який зник з частини на Волині
Жертвою злочинів чи насильсьва він не став

18 листопада, 09:03 Новини
У «Парковому кварталі» в Ковелі – великий вибір комерційних приміщень. ФОТО*
У ЖК “Парковий квартал” (м. Ковель) пропонують комерційні приміщення під магазин чи офіс на першому поверсі нового будинку. Ціна - від 18 000 грн/м2.

18 листопада, 08:58 Новини
Цифри ковіду: оприлюднили статистику щодо недуги в Україні за минулу добу
Ситуація з коронавірусом в Україні стабілізується, але показники захворюваності та смертності тримаються на високому рівні

18 листопада, 08:20 Новини
10-річному хлопчику з Волині, якому поставили діагноз ДЦП, збирають кошти на реабілітацію
10-річний Богданчик з села Ласків Володимир-Волинського району, якому поставили діагноз ДЦП, успішно пройшов перший курс реабілітації.

18 листопада, 07:11 Новини
У Волинській обласній клінічній лікарні більше не буде «благодійних внесків». ВІДЕО
Виконувач обов’язків директора обласної лікарні Олександр Дудар заявив, що ще на початку своєї роботи на посаді ліквідував благодійний фонд

18 листопада, 06:27 Новини
Наставник луцької «Волині» визнаний кращим тренером 18 туру Першої ліги
Всеукраїнське обєднання тренерів з футболу поаналізувало результати чергового 18-ого туру української Першої ліги сезону 2021/22 і визначло кращого тр

18 листопада, 05:15 Новини
Українці обрали ТОП-10 найпопулярніших блогерів
Найбільше у рейтинг потрапило журналістів.

18 листопада, 03:15 Новини
У Польщі нетверезий українець на вантажівці перекинувся з недобудованого моста: штраф буде мільйонний.ФОТО
За попередніми даними, українець не отримав серйозні травми.

18 листопада, 02:32 Новини
Луцькі театрали – у фіналі престижного Всеукраїнського фестивалю
Луцький театр «ГаРмИдЕр» став фіналістом IV Всеукраїнського театрального фестивалю-премії «ГРА» із мультимедійною виставою «Кострубізми. Кумановський»

18 листопада, 01:15 Новини
Збірна України з футболу отримала нового головного тренера
УАФ прибрала "в.о." з посади Олександра Петракова.

18 листопада, 00:31 Новини
У Мінсоцполітики анонсували виплату додаткових грошей з 1 грудня: хто їх отримає
Збільшаться пенсії й виплати на оплату комуналки.

18 листопада, 00:00 Новини
18 листопада на Волині: гортаючи календар
18 листопада народилися депутат Волинської обласної ради Михайло Скопюк, археолог Михайло Вашета та ексдепутат Луцької міської ради Анна Мовяк.



